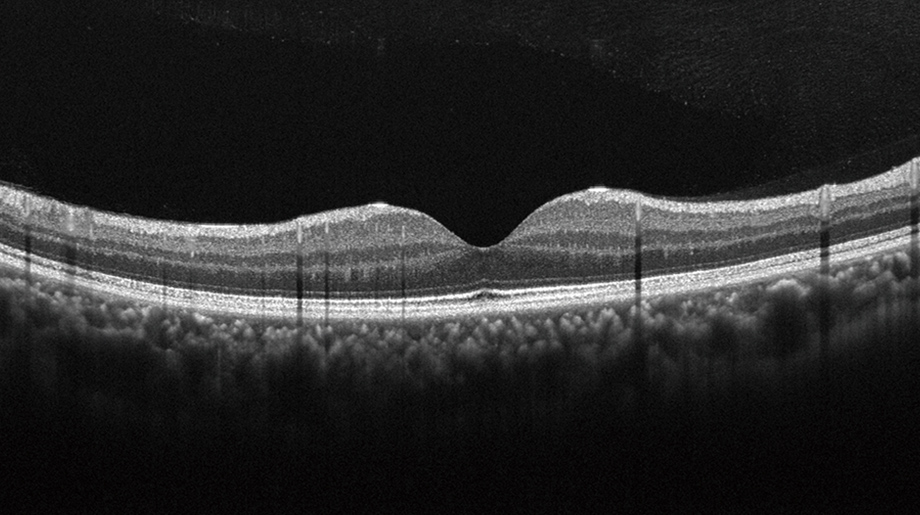
眼底のOCT画像

造影剤を使わずに、眼の疾患を早期発見
光干渉断層計
網膜の断層画像を撮影し、糖尿病による眼の異常や緑内障をはじめとするさまざまな眼の疾患の早期発見に貢献する光干渉断層計(OCT)。レンズやミラーを駆使して光をマイクロメートルレベルで制御。光が「波」である性質を利用することで、高精細な断層画像を撮影します。
目次
光干渉断層計(OCT)のしくみ
OCTとは
光には「波」の性質があり、「干渉」とは、波と波が重なり合うときに波が強め合ったり弱め合ったりする現象をさします。この光の干渉を利用して眼の断層画像を撮影する装置が光干渉断層計(OCT:Optical Coherence Tomography)です。眼底および眼底断層像を観察・撮影・記録でき、加齢黄斑変性や緑内障など、網膜やその周辺に異常が起こる眼科系疾患の早期発見や経過観察に利用されています。
OCTのしくみ
OCTは、光の干渉現象を利用した装置です。光源からさまざまな波長の光を送り、「光カプラ」という複数の光ファイバーを結合・分岐するデバイスを用いて、ミラーに送る光と眼の奥にある網膜に送る光の2つに分けます。ミラーに反射して返ってくる光を基準となる参照光として、網膜の各層から戻ってくる光と参照光を重ねて干渉の強さを測定し、この情報を処理して画像化。網膜の3次元的な構造を映し出すことを可能にしました。

光干渉断層計を支えるキヤノンの技術
キヤノンは、低ノイズで高画質な画像を速く、簡単な操作で実現するOCTを提供し、眼科系疾患の診断における精度向上に貢献しています。
光干渉断層血管撮影(OCTA)
キヤノンの光干渉断層計は、OCTの断層画像から血管の画像を得る「OCT Angiography(アンギオグラフィ)」(以下OCTA)機能を搭載しています。
OCTAは、OCTの信号強度の時間変化を画像化し、血流を高精細に描出する技術です。人によっては強いアレルギー反応が出る造影剤を使用しないため、身体に負担を与えずに、血管の状態を確認することができます。
OCTAでは、同じ場所で時間をずらしたOCT の断層像を複数枚撮影します。この断層像を比較すると、血管のあるところだけは赤血球が動いているために、信号強度が変わります。信号強度が変化した部分を認識し、その部分を血管として抽出し強調して表示することによって、造影剤を使った眼底写真のような眼底血管の画像を得ることができるのです。

OCTA Averaging
「OCTA Averaging」とは、OCTA画像を重ね合わせて加算平均することにより、画像のノイズを目立たなくさせる方法です。同じ撮影位置で複数回撮影した画像を使い、加算平均を用いて背景ノイズを減らし、さらにひずみを補正することで、高コントラストのOCTA画像が得られます。

Intelligent denoise)(AIノイズ低減処理)
ディープラーニング技術を用いたキヤノン独自の新画像処理技術「Intelligent denoise」は、OCTA画像からノイズを除去し、血管の細部まで可視化した高精細OCTA画像を生成する技術です。ディープラーニングに用いる教師データには、OCTA Averagingによる画像を採用しています。Intelligent denoiseにより、わずか1回のスキャンでOCTA Averagingに匹敵する高精細なOCTA画像を生成することができます。


独自のトラッキング技術を採用した広角OCT撮影
キヤノンでは、高速スキャンが可能となるSwept Source(SS)方式を採用し、スキャン幅23mm 深さ約5.3mmの広角・高深達撮影を実現しました。長い波長を高速に照射できるSS光源は、眼底の深いところまで光が到達できますが、その分反射光のデジタル信号を高速に処理しないとタイムリーに画像化できません。キヤノンは高性能なA/D変換ボードを採用して、高速演算による画像化を実現。これまでは強度近視など眼軸長(眼球の前後方向の長さ)が大きい眼底は断層像が正しく描出できませんでしたが、硝子体から網膜・脈絡膜・強膜境界部までの幅広い範囲を一度の撮影で高精細に画像化でき、網膜剥離や出血を発見することを可能にしました。さらに、被験者の眼の動きや瞬きの影響を軽減するキヤノン独自のトラッキング技術を開発し、患者の撮影負荷も軽減しています。

独自の画像処理技術を採用し、高精細な広角OCTA画像が可能に
約80度の広角OCTA撮影により、一度の撮影で、糖尿病網膜症、動静脈閉塞症などの血管異常(無灌流領域や新生血管など)を確認することができ、従来のパノラマ撮影と比較して、被検者の負担が大きく軽減します。さらに、広角OCTAにも「Intelligent Denoise」を適用することで、広範囲でありながら、毛細血管の状態も確認できる高精細な画像取得を可能にしています。

